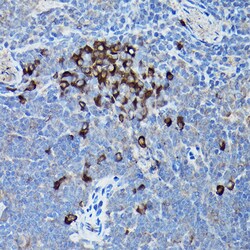
Invitrogen CHOP Polyclonal Antibody 100 &mu;L; Unconjugated:Antibodies,

missing translation for 'onlineSavingsMsg'
Learn More
Learn More
Invitrogen™ CHOP Polyclonal Antibody


Rabbit Polyclonal Antibody
Brand: Invitrogen™ PA588116
This item is not returnable.
View return policy
Description
Positive Samples: C2C12, C6; Cellular Location: Cytoplasm, Nucleus Immunogen sequence: VSPPGNEEEE SKIFTTLDPA SLAWLT.
GADD153 is a small nuclear protein that is capable of dimerizing with transcription factors C/EBP alpha and beta. Once dimerized, this complex inhibits the normal binding and function of C/EBP to classical binding sites. Inversely, the C/EBP GADD153 dimer gains binding activity to other non classical C/EBP stress related targets. Under normal cellular conditions this protein is not expressed in detectable levels, but is highly unregulated during times of cellular/ER stress. Examples of GADD153 inducing stress include: treatment with tunicamycin, nutrient starvation and reducing agents that interfere with the calcium flux across the ER membrane.
Specifications
| CHOP | |
| Polyclonal | |
| Unconjugated | |
| DDIT3 | |
| C/EBP homologous protein; C/EBP homoologous protein 10; C/EBP zeta; C/EBP-homologous protein; C/EBP-homologous protein 10; CCAAT/enhancer-binding protein homologous protein; CEBPZ; CHOP; CHOP10; CHOP-10; Ddit3; DDIT-3; ddit3.L; DNA damage inducible transcript 3; DNA damage inducible transcript 3 L homeolog; DNA damage-inducible transcript 3 protein; DNA-damage inducible transcript 3; DNA-damage-inducible transcript 3; GADD153; growth arrest and DNA damage-inducible; growth arrest and DNA damage-inducible protein GADD153; Growth arrest and DNA-damage-inducible protein GADD153; MGC4154; transcription factor GADD153; Xchop; XELAEV_18013440mg | |
| Rabbit | |
| Affinity Chromatography | |
| RUO | |
| 13198, 1649, 29467 | |
| -20°C, Avoid Freeze/Thaw Cycles | |
| Liquid |
| ELISA, Immunohistochemistry (Paraffin), Immunoprecipitation, Western Blot | |
| 2.38 mg/mL | |
| PBS with 50% glycerol and 0.05% ProClin 300; pH 7.3 | |
| P35638, P35639, Q62857 | |
| DDIT3 | |
| Synthetic peptide. | |
| 100 μL | |
| Primary | |
| Human, Mouse, Rat | |
| Antibody | |
| IgG |
Product Content Correction
Your input is important to us. Please complete this form to provide feedback related to the content on this product.
Product Title
Spot an opportunity for improvement?Share a Content Correction